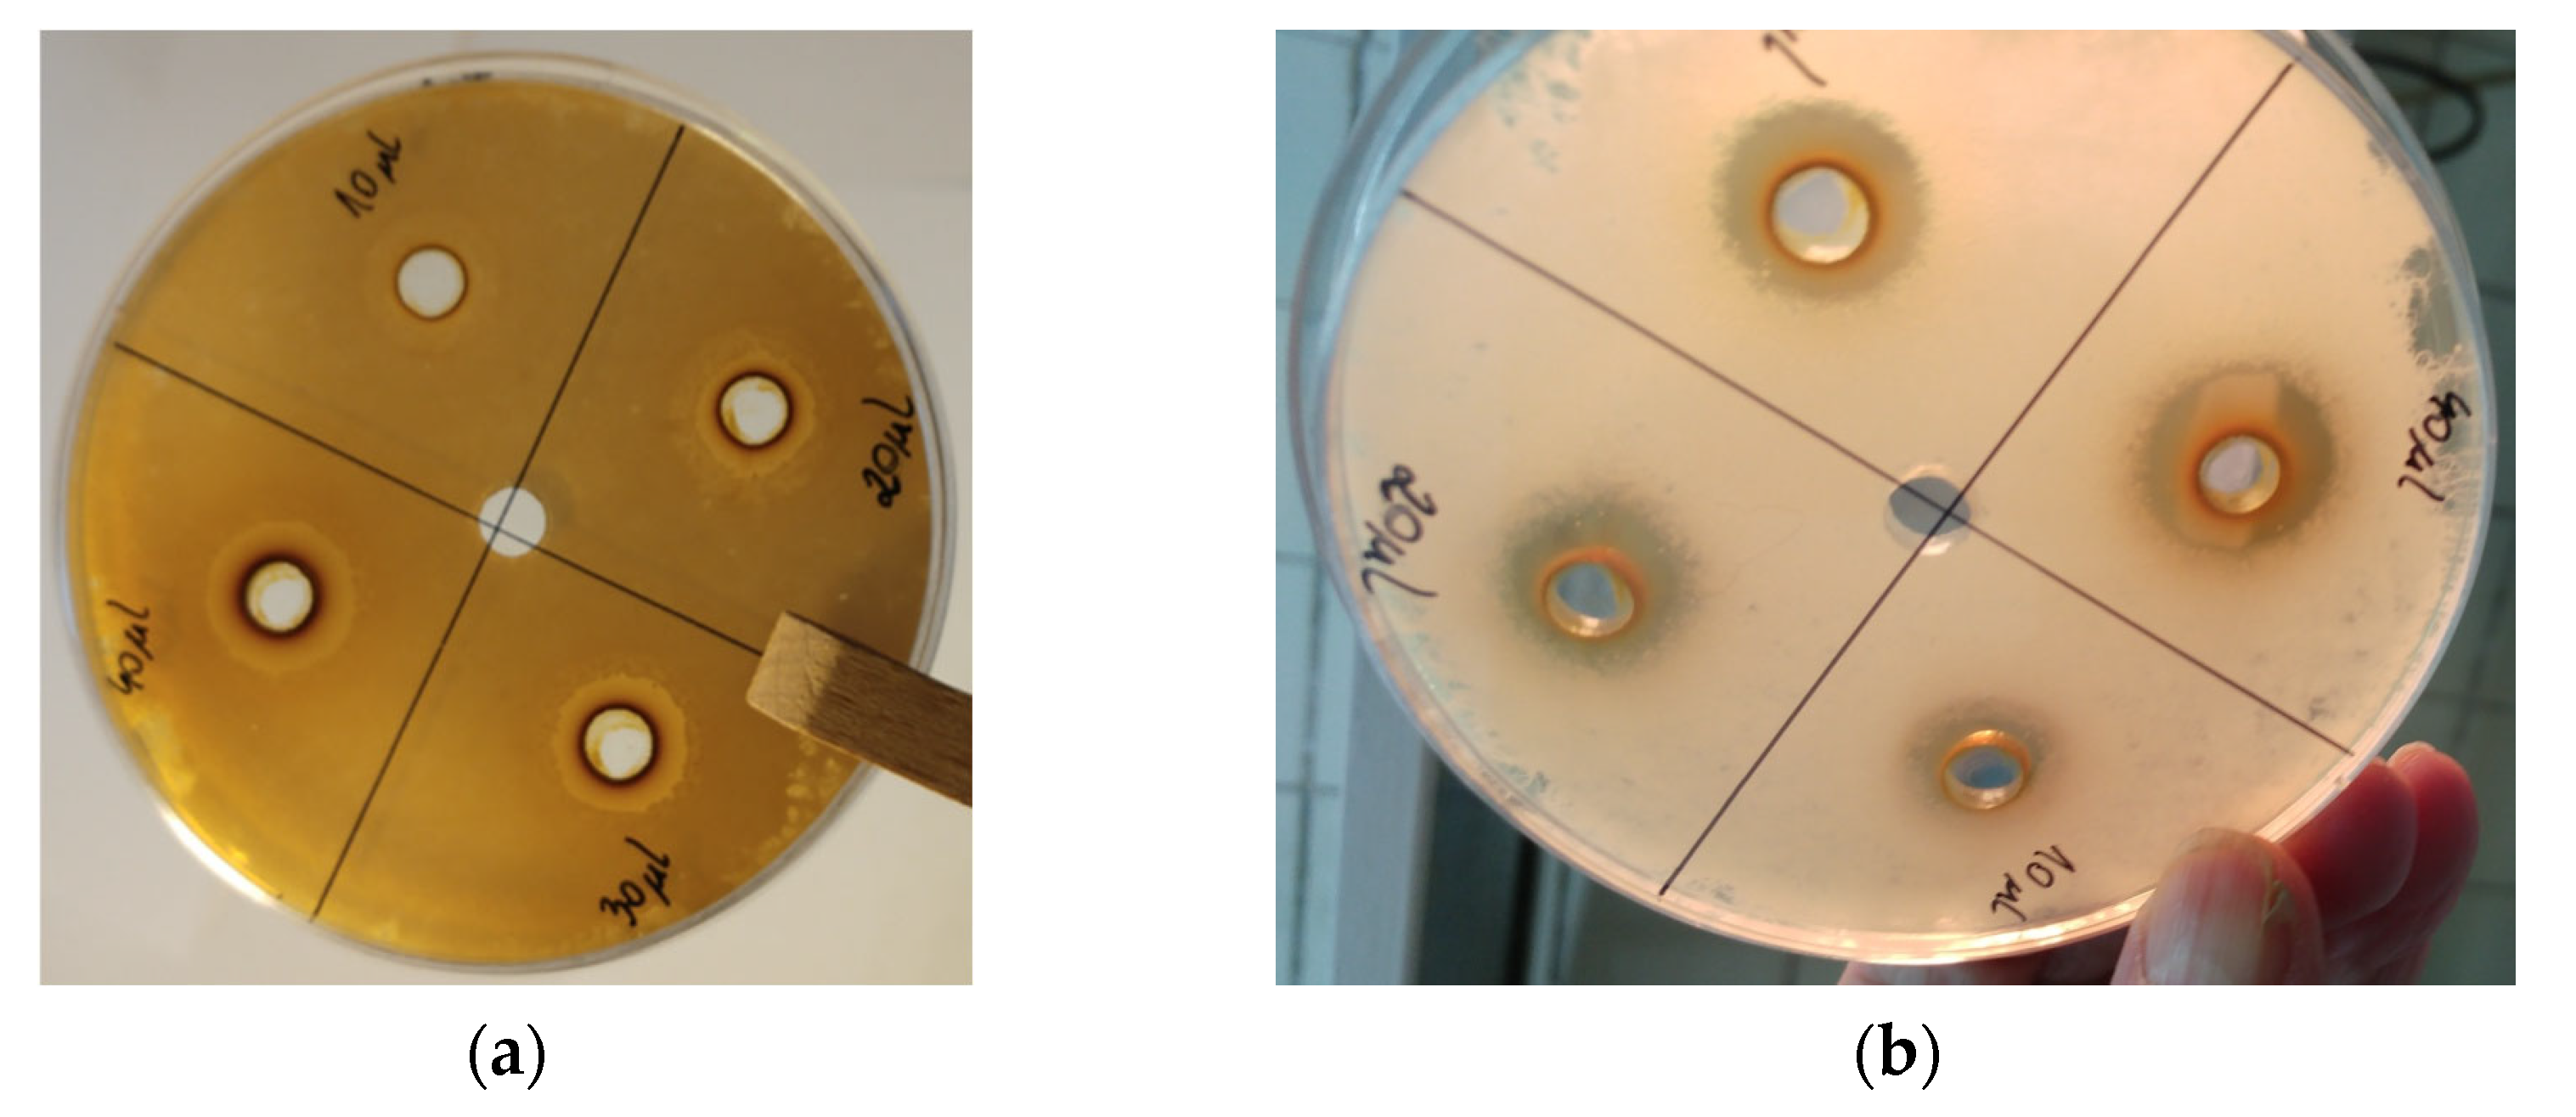

Biologically Active Preparations from the Leaves of Wild Plant Species of the Genus Rubus
Abstract
:1. Introduction
2. Results
2.1. Phytochemical Components of Preparations Obtained from the Leaves of Rubus idaeus L. and Rubus fruticosus L.
2.2. ATR-FTIR Studies
2.3. Evaluation of Free Radical Scavenging Activity
2.4. Surface Disinfection Tests of the Plant Preparations by Standard EN 13697:2019
2.5. Surface Disinfection Tests of Plant Preparations by Standard EN 13697:2015
2.6. Testing of Hand Disinfection by Means of Rubbing in Plant Preparations According to EN 1500:2013
2.7. Biological Activity of Dry Preparations and Antibiotics
2.8. Measurement of Lipophilicity
3. Discussion
4. Materials and Methods
4.1. Materials
4.2. Chemicals
4.3. Plant Preparations from the Leaves of R. idaeus L. and R. fruticosus L.
4.4. Chemical Composition of Preparations from the Leaves of R. idaeus L. and R. fruticosus L.
4.5. ATR-FTIR Studies
4.6. Measurement of Antioxidant Capacity Using DPPH, ABT,S and FRAP Methods
4.7. Measurement of Total Polyphenol Content Using Folin–Ciocalteau Method
4.8. Surface Disinfection Tests of the Plant Preparations by Standard EN 13697:2019
4.9. Surface Disinfection Tests of Plant Preparations by Standard EN 13697:2015
4.10. Testing of Hand Disinfection by Means of Rubbing in Plant Preparations According to EN 1500:2013
4.11. Evaluation of Antimicrobial Activity of Plant Preparations against Isolated Strains of Bacteria, Yeasts, and Fungi
4.11.1. Methods of Application of Plant Preparations to Medium
4.11.2. Methods of Application of Antibiotics to Medium
4.12. Measurement of Lipophilicity of the Natural Preparations
4.13. Statistical Analysis
5. Conclusions
Supplementary Materials
Author Contributions
Funding
Institutional Review Board Statement
Informed Consent Statement
Data Availability Statement
Conflicts of Interest
References
- Kasemsarn, P.; Bosco, J.; Nixon, R.L. The Role of the Skin Barrier in Occupational Skin Diseases. Curr. Probl. Dermatol. 2016, 49, 135–143. [Google Scholar] [CrossRef]
- Lowrey, L.; Woodhams, D.C.; Tacchi, L.; Salinas, I. Topographical Mapping of the Rainbow Trout (Oncorhynchus Mykiss) Microbiome Reveals a Diverse Bacterial Community with Antifungal Properties in the Skin. Appl. Environ. Microbiol. 2015, 81, 6915–6925. [Google Scholar] [CrossRef] [PubMed]
- Zhang, L.; Cao, H.; Li, L.; Zhao, W.; Zhang, F. Oral and External Intervention on the Crosstalk between Microbial Barrier and Skin via Foodborne Functional Component. J. Funct. Foods 2022, 92, 105075. [Google Scholar] [CrossRef]
- Milani, C.; Duranti, S.; Bottacini, F.; Casey, E.; Turroni, F.; Mahony, J.; Belzer, C.; Delgado Palacio, S.; Arboleya Montes, S.; Mancabelli, L.; et al. The First Microbial Colonizers of the Human Gut: Composition, Activities, and Health Implications of the Infant Gut Microbiota. Microbiol. Mol. Biol. Rev. 2017, 81, e00036-17. [Google Scholar] [CrossRef] [PubMed]
- Barbulova, A.; Apone, F.; Colucci, G. Plant Cell Cultures as Source of Cosmetic Active Ingredients. Cosmetics 2014, 1, 94–104. [Google Scholar] [CrossRef]
- Ribeiro, A.S.; Estanqueiro, M.; Oliveira, M.B.; Lobo, J.M.S. Main Benefits and Applicability of Plant Extracts in Skin Care Products. Cosmetics 2015, 2, 48–65. [Google Scholar] [CrossRef]
- Cui, H.; Kong, Y.; Zhang, H. Oxidative Stress, Mitochondrial Dysfunction, and Aging. J. Signal Transduct. 2012, 2012, 646354. [Google Scholar] [CrossRef]
- Michalak, I.; Chojnacka, K. Algae as Production Systems of Bioactive Compounds. Eng. Life Sci. 2015, 15, 160–176. [Google Scholar] [CrossRef]
- Xie, X.; He, Z.; Chen, N.; Tang, Z.; Wang, Q.; Cai, Y. The Roles of Environmental Factors in Regulation of Oxidative Stress in Plant. BioMed Res. Int. 2019, 2019, 21–27. [Google Scholar] [CrossRef]
- Verma, R.; Gangrade, T.; Ghulaxe, C.; Punasiya, R. Rubus Fruticosus (Blackberry) Use as an Herbal Medicine. Pharmacogn. Rev. 2014, 8, 101. [Google Scholar] [CrossRef] [Green Version]
- Kashif, M.; Akhtar, N.; Mustafa, R. An Overview of Dermatological and Cosmeceutical Benefits of Diospyros Kaki and Its Phytoconstituents. Rev. Bras. Farmacogn. 2017, 27, 650–662. [Google Scholar] [CrossRef]
- Vasiliadou, I.A.; Molina, R.; Martínez, F.; Melero, J.A. Biological Removal of Pharmaceutical and Personal Care Products by a Mixed Microbial Culture: Sorption, Desorption and Biodegradation. Biochem. Eng. J. 2013, 81, 108–119. [Google Scholar] [CrossRef]
- Silinsin, M.; Bursal, E. UHPLC-MS/MS Phenolic Profiling and in Vitro Antioxidant Activities of Inula Graveolens (L.) Desf. Nat. Prod. Res. 2018, 32, 1467–1471. [Google Scholar] [CrossRef] [PubMed]
- Nasution, F.; Theanhom, A.A.; Unpaprom, Y.; Ramaraj, R.; Manmai, N.; Chumpookam, J. Muntingia Calabura Fruits as Sources of Bioactive Compounds and Fermentative Ethanol Production. Biomass Convers. Biorefin. 2022. [Google Scholar] [CrossRef]
- Gülçin, I. Antioxidant Activity of Food Constituents: An Overview. Arch. Toxicol. 2012, 86, 345–391. [Google Scholar] [CrossRef]
- Efenberger-Szmechtyk, M.; Nowak, A.; Czyzowska, A. Plant Extracts Rich in Polyphenols: Antibacterial Agents and Natural Preservatives for Meat and Meat Products. Crit. Rev. Food Sci. Nutr. 2021, 61, 149–178. [Google Scholar] [CrossRef]
- Krauze-Baranowska, M.; Majdan, M.; Hałasa, R.; Głód, D.; Kula, M.; Fecka, I.; Orzeł, A. The Antimicrobial Activity of Fruits from Some Cultivar Varieties of Rubus Idaeus and Rubus Occidentalis. Food Funct. 2014, 5, 2536–2541. [Google Scholar] [CrossRef]
- Krzepiłko, A.; Prażak, R.; Święciło, A. Chemical Composition, Antioxidant and Antimicrobial Activity of Raspberry, Blackberry and Raspberry-Blackberry Hybrid Leaf Buds. Molecules 2021, 26, 327. [Google Scholar] [CrossRef]
- Vlad, I.; Goji, G.; Dinulică, F.; Bartha, S.; Vasilescu, M.; Mihăiescu, T. Consuming Blackberry as a Traditional Nutraceutical Resource from an Area with High Anthropogenic Impact. Forests 2019, 10, 246. [Google Scholar] [CrossRef]
- Singh, M.; Purohit, R. Study on Phytochemical Characterization and Antibacterial Activity of Fruit Trees of Chamoli District, Uttarakhand, India. Int. J. Pharm. Biol. Sci. 2019, 9, 226–231. [Google Scholar]
- Riaz, N.; Havel, J.J.; Makarov, V.; Desrichard, A.; Urba, W.J.; Sims, J.S.; Hodi, F.S.; Martín-Algarra, S.; Mandal, R.; Sharfman, W.H.; et al. Tumor and Microenvironment Evolution during Immunotherapy with Nivolumab. Cell 2017, 171, 934–949.e15. [Google Scholar] [CrossRef] [PubMed] [Green Version]
- Meng, Q.; Manghwar, H.; Hu, W. Study on Supergenus Rubus L.: Edible, Medicinal, and Phylogenetic Characterization. Plants 2022, 11, 1211. [Google Scholar] [CrossRef] [PubMed]
- Edewor Theresa, I.; Owa Stephen, O.; Oladipupo, S.S.; Oyelakin, R.A. Determination of the Total Phenolic, Flavonoid Contents; Antioxidant Activity and GC-MS Study of the Leaves of the Medicinal Plant Sarcocephalus Latifolius. Int. J. Pharm. Sci. Rev. Res. 2015, 34, 82–86. [Google Scholar]
- Menegazzo, F.; Ghedini, E.; Signoretto, M. 5-Hydroxymethylfurfural (HMF) Production from Real Biomasses. Molecules 2018, 23, 2201. [Google Scholar] [CrossRef] [PubMed]
- Mascal, M.; Nikitin, E.B. High-Yield Conversion of Plant Biomass into the Key Value-Added Feedstocks 5-(Hydroxymethyl)Furfural, Levulinic Acid, and Levulinic Esters via 5-(Chloromethyl)Furfural. Green Chem. 2010, 12, 370–373. [Google Scholar] [CrossRef]
- Bellincontro, A.; De Santis, D.; Botondi, R.; Villa, I.; Mencarelli, F. Different Postharvest Dehydration Rates Affect Quality Characteristics and Volatile Compounds of Malvasia, Trebbiano and Sangiovese Grapes for Wine Production. J. Sci. Food Agric. 2004, 84, 1791–1800. [Google Scholar] [CrossRef]
- Bueno, P.I.; Machado, D.; Lancellotti, M.; Gonçalves, C.P.; Marcucci, M.C.; Sawaya, A.C.H.F.; Melo, A. de In Silico Studies, Chemical Composition, Antibacterial Activity and in Vitro Antigen-Induced Phagocytosis of Stryphnodendron Adstringens (Mart.) Coville. Res. Soc. Dev. 2022, 11, e35911225748. [Google Scholar] [CrossRef]
- Costantini, V.; Bellincontro, A.; De Santis, D.; Botondi, R.; Mencarelli, F. Metabolic Changes of Malvasia Grapes for Wine Production during Postharvest Drying. J. Agric. Food Chem. 2006, 54, 3334–3340. [Google Scholar] [CrossRef]
- Zeng, K.; Thompson, K.E.; Yates, C.R.; Miller, D.D. Synthesis and Biological Evaluation of Quinic Acid Derivatives as Anti-Inflammatory Agents. Bioorg. Med. Chem. Lett. 2009, 19, 5458–5460. [Google Scholar] [CrossRef]
- de Souza, F.G.; de Araújo, F.F.; Orlando, E.A.; Rodrigues, F.M.; Chávez, D.W.H.; Pallone, J.A.L.; Neri-Numa, I.A.; Sawaya, A.C.H.F.; Pastore, G.M. Characterization of Buritirana (Mauritiella armata) Fruits from the Brazilian Cerrado: Biometric and Physicochemical Attributes, Chemical Composition and Antioxidant and Antibacterial Potential. Foods 2022, 11, 786. [Google Scholar] [CrossRef]
- Krishnaveni, M.; Dhanalakshmi, R.; Nandhini, N. GC-MS Analysis of Phytochemicals, Fatty Acid Profile, Antimicrobial Activity of Gossypium Seeds. Int. J. Pharm. Sci. Rev. Res. 2014, 27, 273–276. [Google Scholar]
- Balaji, M.; Thamilvanan, D.; Chidambara Vinayagam, S.; Balakumar, B.S. Anticancer, antioxidant activity and gc-ms analysis of selected micro algal members of chlorophyceae. Int. J. Pharm. Sci. Res. 2017, 13, 3302–3314. [Google Scholar]
- Zeng, Q.Y.; Wu, J.; Lin, P.C. Chemical Composition and Antimicrobial Activity of the Essential Oil from Epilobium Angustifolium. Chem. Nat. Compd. 2016, 52, 1113–1115. [Google Scholar] [CrossRef]
- Nowak, A.; Ossowicz-Rupniewska, P.; Rakoczy, R.; Konopacki, M.; Perużyńska, M.; Droździk, M.; Makuch, E.; Duchnik, W.; Kucharski, Ł.; Wenelska, K.; et al. Bacterial Cellulose Membrane Containing Epilobium Angustifolium l. Extract as a Promising Material for the Topical Delivery of Antioxidants to the Skin. Int. J. Mol. Sci. 2021, 22, 6269. [Google Scholar] [CrossRef]
- Makuch, E.; Nowak, A.; Günther, A.; Pełech, R.; Kucharski, Ł.; Duchnik, W.; Klimowicz, A. The Effect of Cream and Gel Vehicles on the Percutaneous Absorption and Skin Retention of a New Eugenol Derivative with Antioxidant Activity. Front. Pharmacol. 2021, 12, 658381. [Google Scholar]
- Kurt, A.; Kaya, E. Medical and Cosmetic Applications of Persimmon (Diospyros Kaki): Toxicity Assessment-A review. IJTCMR 2020, 1, 162–176. [Google Scholar]
- Yang, C.-H.; Li, R.-X.; Chuang, L.-Y. Antioxidant Activity of Various Parts of Cinnamomum Cassia Extracted with Different Extraction Methods. Molecules 2012, 17, 7294–7304. [Google Scholar] [CrossRef]
- Nowak, A.; Klimowicz, A.; Duchnik, W.; Kucharski, Ł.L.; Florkowska, K.; Muzykiewicz, A.; Wira, D.; Zielonkabrzezicka, J.; Siedłowska, A.; Nadarzewska, K. Application of Green-Extraction Technique to Evaluate of Antioxidative Capacity of Wild Population of Fireweed (Epilobium Angustifolium). Herba Pol. 2020, 65, 18–30. [Google Scholar] [CrossRef]
- Toure, H.A.; Bouatia, M.; Idrissi, M.O.B.; Draoui, M. Phytochemical Screening and Antioxidant Activity of Aqueous-Ethanolic Extracts of Opuntia Ficus Indica. J. Chem. Pharm. Res. 2015, 7, 409–415. [Google Scholar]
- Prasad, K.N.; Yang, B.; Dong, X.; Jiang, G.; Zhang, H.; Xie, H.; Jiang, Y. Flavonoid Contents and Antioxidant Activities from Cinnamomum Species. Innov. Food Sci. Emerg. Technol. 2009, 10, 627–632. [Google Scholar] [CrossRef]
- Nowak, A.; Cybulska, K.; Makuch, E.; Kucharski, Ł.; Różewicka-Czabańska, M.; Prowans, P.; Czapla, N.; Bargiel, P.; Petriczko, J.; Klimowicz, A. In Vitro Human Skin Penetration, Antioxidant and Antimicrobial Activity of Ethanol-Water Extract of Fireweed (Epilobium angustifolium L.). Molecules 2021, 26, 329. [Google Scholar] [CrossRef]
- Garzón, G.A.; Riedl, K.M.; Schwartz, S.J. Determination of Anthocyanins, Total Phenolic Content, and Antioxidant Activity in Andes Berry (Rubus Glaucus Benth). J. Food Sci. 2009, 74, C227–C232. [Google Scholar] [CrossRef] [PubMed]
- de Lucas, A.; Martinez de la Ossa, E.; Rincón, J.; Blanco, M.A.; Gracia, I. Supercritical fluid extraction of tocopherol concentrates from olive tree leaves. J. Supercrit. Fluids 2002, 22, 221–228. [Google Scholar]
- Benvenuti, S.; Pellati, F.; Melegari, M.; Bertelli, D. Polyphenols, Anthocyanins, Ascorbic Acid, and Radical Scavenging Activity of Rubus, Ribes, and Aronia. J. Food Sci. 2006, 69, FCT164–FCT169. [Google Scholar] [CrossRef]
- Rotundo, A.; Bounous, G.; Benvenuti, S.; Vampa, G.; Melegari, M.; Soragni, F. Quality and Yield of Ribes and Rubus Cultivars Grown in Southern Italy Hilly Locations. Phytother. Res. 1998, 12, S135–S137. [Google Scholar] [CrossRef]
- Kaškoniene, V.; Stankevičius, M.; Drevinskas, T.; Akuneca, I.; Kaškonas, P.; Bimbiraite-Surviliene, K.; Maruška, A.; Ragažinskiene, O.; Kornyšova, O.; Briedis, V.; et al. Evaluation of Phytochemical Composition of Fresh and Dried Raw Material of Introduced Chamerion Angustifolium L. Using Chromatographic, Spectrophotometric and Chemometric Techniques. Phytochemistry 2015, 115, 184–193. [Google Scholar] [CrossRef] [PubMed]
- Pillai, S.; Oresajo, C.; Hayward, J. Ultraviolet Radiation and Skin Aging: Roles of Reactive Oxygen Species, Inflammation and Protease Activation, and Strategies for Prevention of Inflammation-Induced Matrix Degradation—A Review. Int. J. Cosmet. Sci. 2005, 27, 17–34. [Google Scholar] [CrossRef]
- Momodu, I.B.; Okungbowa, E.S.; Agoreyo, B.O.; Maliki, M.M. Gas Chromatography—Mass Spectrometry Identification of Bioactive Compounds in Methanol and Aqueous Seed Extracts of Azanza Garckeana Fruits. Niger. J. Biotechnol. 2022, 38, 25–38. [Google Scholar] [CrossRef]
- Canli, K.; Yetgin, A.; Akata, I.; Altuner, E.M. Antimicrobial Activity and Chemical Composition Screening of Epilobium Montanum Root. Indian J. Pharm. Educ. Res. 2017, 51, S239–S243. [Google Scholar] [CrossRef]
- Oszmiański, J.; Wojdyło, A.; Nowicka, P.; Teleszko, M.; Cebulak, T.; Wolanin, M. Determination of Phenolic Compounds and Antioxidant Activity in Leaves from Wild Rubus L. Species. Molecules 2015, 20, 4951–4966. [Google Scholar] [CrossRef]
- Mostafa, A.A.; Al-Askar, A.A.; Almaary, K.S.; Dawoud, T.M.; Sholkamy, E.N.; Bakri, M.M. Antimicrobial Activity of Some Plant Extracts against Bacterial Strains Causing Food Poisoning Diseases. Saudi J. Biol. Sci. 2018, 25, 361–366. [Google Scholar] [CrossRef] [PubMed]
- Rojas-Vera, J.; Patel, A.V.; Dacke, C.G. Relaxant Activity of Raspberry (Rubus Idaeus) Leaf Extract in Guinea-Pig Ileum in Vitro. Phytother. Res. 2002, 16, 665–668. [Google Scholar] [CrossRef] [PubMed]
- Makuch, E.; Nowak, A.; Günther, A.; Pełech, R.; Kucharski, Ł.; Duchnik, W.; Klimowicz, A. Enhancement of the Antioxidant and Skin Permeation Properties of Eugenol by the Esterification of Eugenol to New Derivatives. AMB Express 2020, 10, 187. [Google Scholar]
- Peksel, A.; Arisan-Atac, I.; Yanardag, R. Evaluation of antioxidant and antiacetylcholinesterase activities of the extracts of pistacia atlantica desf. leaves. J. Food Biochem. 2010, 34, 451–476. [Google Scholar] [CrossRef]
- Lissi, E.A.; Modak, B.; Torres, R.; Escobar, J.; Urzua, A. Total Antioxidant Potential of Resinous Exudates from Heliotrapium Species, and a Comparison of the ABTS and DPPH Methods. Free. Radic. Res. 1999, 30, 471–477. [Google Scholar] [CrossRef]
- Benzie, I.F.F.; Strain, J.J. The Ferric Reducing Ability of Plasma (FRAP) as a Measure of “Antioxidant Power”: The FRAP Assay. Anal. Biochem. 1996, 239, 70–76. [Google Scholar] [CrossRef]
- Perugini, P.; Bonetti, M.; Guerini, M.; Musitelli, G.; Grisoli, P. A New In Vitro Model to Evaluate Anti-Adhesive Effect against Fungal Nail Infections. Appl. Sci. 2021, 11, 1977. [Google Scholar] [CrossRef]
- Osama, A.; Awadelkarim, S.; Omer, M.; Yasser, S.; Basher, Y.; Elmabrouk, T.; Abdalmaged, A. Antimicrobial activity and elemental composition of Sarcocephalus latifolius fruits: An ethnopharmacological based evaluation. JAMB 2017, 3, 1–5. [Google Scholar]
- Özer, Z.; Gören, A.C.; Kılıç, T.; Öncü, M.; Çarıkçı, S.; Dirmenci, T. The Phenolic Contents, Antioxidant and Anticholinesterase Activity of Section Amaracus (Gled.) Vogel and Anatolicon Ietsw. of Origanum L. Species. Arab. J. Chem. 2020, 13, 5027–5039. [Google Scholar] [CrossRef]
- Bauters, T.; Mondelaers, V.; Robays, H.; De Wilde, H.; Benoit, Y.; De Moerloose, B. Methemoglobinemia and Hemolytic Anemia after Rasburicase Administration in a Child with Leukemia. Pancreas 2011, 33, 58–60. [Google Scholar] [CrossRef]
- Bajer, T.; Šilha, D.; Ventura, K.; Bajerová, P. Composition and Antimicrobial Activity of the Essential Oil, Distilled Aromatic Water and Herbal Infusion from Epilobium Parviflorum Schreb. Ind. Crops Prod. 2017, 100, 95–105. [Google Scholar] [CrossRef]
- Günther, A.; Makuch, E.; Nowak, A.; Duchnik, W.; Kucharski, Ł.; Pełech, R.; Klimowicz, A. Enhancement of the Antioxidant and Skin Permeation Properties of Betulin and Its Derivatives. Molecules 2021, 26, 3435. [Google Scholar] [CrossRef] [PubMed]
- Brand-Williams, W.; Cuvelier, M.E.; Berset, C.L.W.T. Use of Free Radical Method to Evaluate Antioxidant Activity. LWT Food Sci. Technol. 1995, 28, 25–30. [Google Scholar] [CrossRef]
- Lee, H.H.; Hong, S.I.; Kim, D. Microbial Reduction Efficacy of Various Disinfection Treatments on Fresh-Cut Cabbage. Food Sci. Nutr. 2014, 2, 585–590. [Google Scholar] [CrossRef] [PubMed]
- Falcó, I.; Verdeguer, M.; Aznar, R.; Sánchez, G.; Randazzo, W. Sanitizing Food Contact Surfaces by the Use of Essential Oils. Innov. Food Sci. Emerg. Technol. 2019, 51, 220–228. [Google Scholar] [CrossRef]
- Villa, C.; Russo, E. Hydrogels in Hand Sanitizers. Materials 2021, 14, 1577. [Google Scholar] [CrossRef]
- Valgas, C.; De Souza, S.M.; Smânia, E.F.A.; Smânia, A. Screening Methods to Determine Antibacterial Activity of Natural Products. Braz. J. Microbiol. 2007, 38, 369–380. [Google Scholar] [CrossRef] [Green Version]

| Chemical Compound | Retention Time (min) | Formula | Biological Activity |
|---|---|---|---|
| 2-hexenal 1,2 | 5.18 | C6H10O | - |
| 2-Heptanone 1,2 | 5.31 | C7H14O | - |
| 2-hexanol-3-methyl 1,2 | 5.41 | C7H16O | - |
| 4-heptanol-3-ethyl 1,2 | 5.56 | C9H20O | - |
| 3-hexanol-5-methyl 1,2 | 7.81 | C7H16O | - |
| 4H-pyran-4-one 1,2 | 10.48 | C6H8O4 | - [23] |
| 5-(hydroxymethyl)furfural 1,2 | 11.58 | C6H6O3 | - [35,41] |
| 2,4-heptadienal 1,2 | 12.98 | C7H10O | antimicrobial, antifungal [42,43] |
| 2-honanone 1,2 | 13.69 | C9H18O | |
| Pyrogallol 1,2 | 14.54 | C6H6O3 | multi-directional biological activity [42,43,44] |
| 2-hydroxy-5-methylbenzaldehyde 2 | 14.59 | C8H8O2 | - [23] |
| n-decanoic acid 2 | 16.51 | C10H20O2 | antifungal, antibacterial [42,43] |
| quinic acid 2 | 17.01 | C7H12O6 | antioxidant, anti-inflammatory [45,46] |
| dodecanoic acid 1,2 | 19.58 | C12H24O2 | antifungal, antibacterial [42,43] |
| hexadecanoic acid 1,2 | 20.60 | C16H32O2 | antioxidant, anti-inflammatory, antibacterial [9,47,48] |
| linoleic acid methyl ester 1,2 | 22.37 | C19H32O2 | antibacterial, antifungal [6,9,46,48] |
| Antioxidant Activity: | Total Polyphenol Content: | |||
|---|---|---|---|---|
| Preparations | DPPH | ABTS | FRAP | F-C |
| (mg Trolox/g Raw Material) | (mg GA/g Raw Material) | |||
| P1 Rubus idaeus L. * | 3.38 ± 0.03 a | 17.89 ± 1.07 b | 6.13 ± 0.17 a | 6.52 ± 0.57 ab |
| P2 Rubus fruticosus L. * | 3.43 ± 0.02 ab | 20.01 ± 0.20 a | 7.39 ± 0.13 ab | 7.55 ± 0.43 a |
| EN 13697:2019 (Phase 2 Stage 2) | |||||||
|---|---|---|---|---|---|---|---|
| Test Preparation | Treatment | Staphylococcus aureus ATCC 6538 | Pseudomonas aeruginosa ATCC 15442 | Escherichia coli ATCC 10536 | Enterococcus hirae ATCC 10541 | Candida albicans ATCC 10231 | Aspergillus brasiliensis ATCC 16404 |
| LR/% reduction P1 Concentration 0.6 g/100 mL | contact time 60 ± 10 s | 1.45 ± 0.06b/>96.4 | 1.44 ± 0.04c/>96.3 | 1.42 ± 0.01a/>96.1 | 1.38 ± 0.11a/>95.8 | 0.42 ± 0.10b/>61.9 | 0.60 ± 0.03c/>74.8 |
| LR/% reduction P1 Concentration 60 g/100 mL | >4.83/ >99.9 | >4.81/ >99.9 | >4.79/ >99.9 | >4.08/ >99.9 | >3.79/ >99.9 | >3.67/ >99.9 | |
| LR/% reduction P1 Concentration 60 g/100 mL | contact time 300 ± 10 s | >4.83/ >99.9 | >4.81/ >99.9 | >4.79/ >99.9 | >4.76/ >99.9 | >3.79/ >99.9 | >3.67/ >99.9 |
| LR/% reduction P2 Concentration 0.6 g/100 mL | contact time 60 ± 10 s | 1.42 ± 0.06b/ >96.1 | 1.35 ± 0.12a/ >95.5 | 1.38 ± 0.11c/ >95.8 | 1.39 ± 0.14a/ >95.9 | 0.62 ± 0.11d/ >76.0 | 0.41 ± 0.18a/ >61.0 |
| LR/% reduction P2 Concentration 60 g/100 mL | 3.90 ± 0.04a/ >99.9 | >4.72/ >99.9 | >4.75/ >99.9 | >4.76/ >99.9 | >3.69/ >99.9 | >3.78/ >99.9 | |
| LR/% reduction P2 Concentration 60 g/100 mL | contact time 300 ± 10 s | >4.79/ >99.9 | >4.72/ >99.9 | >4.75/ >99.9 | >4.76/ >99.9 | >3.69/ >99.9 | >3.78/ >99.9 |
| EN 13697: 2015 (Phase 2 Stage 2) | |||
|---|---|---|---|
| Test Preparation | Treatment | Staphylococcus aureus ATCC 6538 | Pseudomonas aeruginosa ATCC 15442 |
| Preparation 1 (P1) | |||
| LR/% reduction Concentration of P1 14 g/100 mL | contact time 60 ± 10 s | 1.74 ± 0.09 b/>98.1 | 1.73 ± 0.14 a/>98.1 |
| LR/% reduction Concentration of P1 21 g/100 mL | 1.98 ± 0.07 c/>98.9 | 1.83 ± 0.04 b/>98.5 | |
| LR/% reduction Concentration of P1 28 g/100 mL | 2.25 ± 0.06 a/>99.4 | 2.21 ± 0.01 a/>99.3 | |
| LR/% reduction Concentration of P1 35 g/100 mL | 3.28 ± 0.10 b/>99.9 | 2.47 ± 0.08 a/>99.6 | |
| LR/% reduction Concentration of P1 42 g/100 mL | 4.35 ± 0.13 c/>99.9 | 3.70 ± 0.09 c/>99.9 | |
| LR/% reduction Concentration of P1 49 g/100 mL | 4.78 ± 0.04 a/>99.9 | 4.75 ± 0.11 d/>99.9 | |
| LR/% reduction Concentration of P1 56 g/100 mL | >7.10/>99.9 | >7.11/>99.9 | |
| LR/% reduction Concentration of P1 63 g/100 mL | >7.10/>99.9 | >7.11/>99.9 | |
| LR/% reduction Concentration of P1 70 g/100 mL | >7.10/>99.9 | >7.11/>99.9 | |
| Preparation 2 (P2) | |||
| LR/% reduction Concentration of P2 14 g/100 mL | contact time 60 ± 10 s | 1.84 ± 0.01 b/>98.5 | 1.76 ± 0.05 b/>98.2 |
| LR/% reduction Concentration of P2 21 g/100 mL | 2.19 ± 0.06 a/>99.3 | 1.92 ± 0.09 a/>98.7 | |
| LR/% reduction Concentration of P2 28 g/100 mL | 2.31 ± 0.07 d/>99.5 | 2.35 ± 0.02 b/>99.5 | |
| LR/% reduction Concentration of P2 35 g/100 mL | 4.46 ± 0.01 c/>99.9 | 4.31 ± 0.09 b/>99.9 | |
| LR/% reduction Concentration of P2 42 g/100 mL | >7.12/>99.9 | >7.08/>99.9 | |
| LR/% reduction Concentration of P2 49 g/100 mL | >7.12/>99.9 | >7.08/>99.9 | |
| LR/% reduction Concentration of P1 56 g/100 mL | >7.12/>99.9 | >7.08/>99.9 | |
| LR/% reduction Concentration of P2 63 g/100 mL | >7.12/>99.9 | >7.08/>99.9 | |
| LR/% reduction Concentration of P2 70 g/100 mL | >7.12/>99.9 | >7.08/>99.9 | |
| Ethanol (E) | |||
| LR/% reduction Concentration of E 80 g/100 mL | 3.93 ± 0.05 b/>99.9 | 3.93 ± 0.07 c/>99.9 | |
| LR/% reduction Concentration of E 90 g/100 mL | >7.11/>99.9 | >7.11/>99.9 | |
| LR/% reduction Concentration of E 100 g/100 mL | >7.11/>99.9 | >7.11/>99.9 | |
| Tester Number | LR | PR-P1 | LR | PR-P2 | ||
|---|---|---|---|---|---|---|
| PR | P1 | PR | P2 | |||
| 1 | 3.39 ± 0.11 a | 4.31 ± 0.01 a | −0.92 ± 0.05 a | 3.39 ± 0.11 d | 3.24 ± 0.12 d | 0.15 ± 0.14 b |
| 2 | 4.45 ± 0.09 a | 4.76 ± 0.01 a | −0.30 ± 0.05 b | 4.45 ± 0.19 d | 4.54 ± 0.09 cd | −0.09 ± 0.20 c |
| 3 | 4.41 ± 0.08 ab | 4.52 ± 0.03 ab | −0.12 ± 0.4 ab | 4.41 ± 0.06 c | 4.44 ± 0.05 c | −0.03 ± 0.08 c |
| 4 | 3.69 ± 0.21 a | 3.83 ± 0.06 b | −0.13 ± 0.12 ab | 3.69 ± 0.11 cd | 3.59 ± 0.03 c | 0.11 ± 0.06 c |
| 5 | 3.17 ± 0.19 a | 3.68 ± 0.09 c | −0.50 ± 0.012 a | 3.17 ± 0.13 cd | 3.51 ± 0.01 b | −0.34 ± 0.06 bc |
| 6 | 3.99 ± 0.08 ab | 4.07 ± 0.21 c | −0.08 ± 0.02 ab | 3.99 ± 0.14 cd | 3.74 ± 0.09 bc | 0.24 ± 0.21 d |
| 7 | 4.91 ± 0.16 ab | 4.09 ± 0.08 bc | 0.82 ± 0.04 b | 4.91 ± 0.10 e | 5.82 ± 0.06 cd | −0.90 ± 0.12 d |
| 8 | 3.14 ± 0.19 b | 3.26 ± 0.03 ab | −0.12 ± 0.02 a | 3.14 ± 0.23 e | 3.06 ± 0 d | 0.08 ± 0.04 e |
| 9 | 3.48 ± 0.17 ab | 4.06 ± 0.04 bc | −0.58 ± 0.05 ab | 3.48 ± 0.05 e | 4.04 ± 0.21 cd | −0.56 ± 0.01 e |
| 10 | 3.78 ± 0.04 a | 4.09 ± 0.05 bc | −0.32 ± 0.21 c | 3.78 ± 0.05 de | 3.64 ± 0.12 ab | 0.14 ± 0.10 de |
| 11 | 3.85 ± 0.09 c | 4.22 ± 0.04 cd | −0.37 ± 0.20 d | 3.85 ± 0.08 d | 4.54 ± 0.10 d | −0.69 ± 0.05 c |
| 12 | 3.93 ± 0.11 c | 3.98 ± 0.03 ab | −0.04 ± 0.12 ab | 3.93 ± 0.14 c | 3.67 ± 0.07 c | 0.27 ± 0.10 d |
| 13 | 3.49 ± 0.13 d | 3.99 ± 0.09 cd | −0.50 ± 0.05 ab | 3.49 ± 0.19 d | 3.61 ± 0.12 a | −0.13 ± 0.12 cd |
| 14 | 3.56 ± 0.11 cd | 3.94 ± 0.03 de | −0.38 ± 0.18 e | 3.56 ± 0.12 de | 3.61 ± 0.08 c | −0.05 ± 0.10 e |
| 15 | 3.49 ± 0.19 e | 3.91 ± 0.04 d | −0.43 ± 0.13 c | 3.49 ± 0.09 c | 3.74 ± 0.08 a | −0.26 ± 0.12 a |
| 16 | 3.37 ± 0.12 ab | 3.51 ± 0.08 e | −0.14 ± 0.10 b | 3.37 ± 0.04 b | 3.32 ± 0.06 b | 0.05 ± 0.14 b |
| 17 | 3.73 ± 0.19 bc | 4.74 ± 0.08 d | −1.01 ± 0.13 de | 3.73 ± 0.02 b | 3.65 ± 0.05 b | 0.08 ± 0.11 ab |
| 18 | 3.69 ± 0.18 b | 4.01 ± 0.01 de | −0.32 ± 0.15 ab | 3.69 ± 0.10 bc | 3.62 ± 0.09 b | 0.07 ± 0.06 cd |
| 19 | 3.65 ± 0.10 b | 4.07 ± 0.03 de | −0.43 ± 0.10 b | 3.65 ± 0.13 bc | 3.60 ± 0.05 b | 0.05 ± 0.07 c |
| 20 | 3.70 ± 0.10 b | 4.12 ± 0.05 b | −0.42 ± 0.04 ab | 3.70 ± 0.21 de | 3.50 ± 0.20 a | 0.20 ± 0.05 d |
| Bacterial/Symbol | R. idaeus | R. fruticosus | Doxycycline | Ampicillin | Ciprofloxacin |
|---|---|---|---|---|---|
| The Diameter of the Growth Inhibition Zone (mm) | |||||
| Escherichia coli ATCC25922 | 8.7 ± 0.32 c | 8.3 ± 0.30 c | 20.0 ± 0.30 b | 20.3 ± 0.30 b | 25.0 ± 0.32 a |
| Enterococcus faecalis ATCC29212 | 15.0 ± 0.39 c | 18.3 ± 0.12 c | 35.0 ± 0.12 a | 18.3 ± 0.12 c | 24.7 ± 0.06 b |
| Klebsiella pneumoniae ATCC700603 | 8.3 ± 0.30 bc | 6.3 ± 0.32 cd | 5.7 ± 0.52 d | 9.7 ± 0.58 b | 19.3 ± 0.01 a |
| Pseudomonas aeruginosa ATCC27853 | 8.7 ± 0.50 d | 6.0 ± 0.30 d | 49.7 ± 1.04 a | 38.3 ± 0.06 b | 31.7 ± 0.58 c |
| Salmonella typhimurium ATCC14028 | 7.0 ± 0.55 d | 6.0 ± 0.52 d | 30.3 ± 0.58 b | 17.7 ± 0.30 c | 37.0 ± 0.12 a |
| Staphylococcus aureus (A) ATCC29213 | 16.7 ± 0.06 c | 18.0 ± 0.12 c | 21.7 ± 0.30 bc | 26.7 ± 0.32 ab | 28.3 ± 0.58 a |
| Staphylococcus aureus (B) ATCC25923 | 17.3 ± 0.01 c | 15.3 ± 0.58 c | 41.7 ± 1.00 a | 35.3 ± 0.12 b | 33.7 ± 0.50 b |
| Streptococcuspneumoniae ATCC49619 | 6.3 ± 0.15 d | 6.0 ± 0.06 d | 36.3 ± 0.30 a | 20.0 ± 0.52 c | 32.3 ± 0.55 b |
| Streptococcus intermedius ATCC29663 | 21.7 ± 0.59 c | 19.7 ± 1.00 c | 54.3 ± 2.00 a | 35.3 ± 0.30 b | 32.0 ± 0.06 b |
| Sarcina lutea ATCC9341 | 18.0 ± 0.58 d | 14.3 ± 0.30 de | 54.0 ± 0.01 a | 35.0 ± 0.32 b | 26.7 ± 0.12 c |
| Bacillus subtilis | 14.0 ± 0.52 b | 15.8 ± 0.52 b | 32.3 ± 0.30 a | 31.7 ± 0.30 a | 34.3 ± 0.52 a |
| Bacillus pseudomycoides | 15.3 ± 0.80 d | 12.7 ± 0.30 d | 25.3 ± 0.58 c | 30.0 ± 0.30 b | 37.3 ± 0.30 a |
| Bacillis thuringiensis | 15. 0 ± 0.12 c | 12.3 ± 0.05 c | 14.3 ± 0.30 c | 30.0 ± 0.30 b | 34.3 ± 0.32 a |
| EN 13697:2019 (Phase 2 Stage 2) | |||||||
|---|---|---|---|---|---|---|---|
| Test Preparation | Treatment | Staphylococcus aureus ATCC 6538 | Pseudomonas aeruginosa ATCC 15442 | Escherichia coli ATCC 10536 | Enterococcus hirae ATCC 10541 | Candida albicans ATCC 10231 | Aspergillus brasiliensis ATCC 16404 |
| Preparation 1 (P1) | |||||||
| N | 7.04 ± 0.41 b | 6.99 ± 0.10 ab | 6.98 ± 0.17 ab | 7.06 ± 0.11 bc | 5.90 ± 0.23 a | 6.01 ± 0.10 ab | |
| NT | 6.94 ± 0.43 b | 6.92 ± 0.31 ab | 6.91 ± 0.19 c | 6.86 ± 0.14 a | 5.79 ± 0.18 ab | 5.92 ± 0.17 ab | |
| NC | 6.95 ± 0.49 b | 6.90 ± 0.21 ab | 6.92 ± 0.25 bc | 6.89 ± 0.07 b | 5.79 ± 0.13 bc | 5.91 ± 0.20 ab | |
| NW | 6.97 ± 0.37 a | 6.96 ± 0.17 b | 6.94 ± 0.24 c | 6.90 ± 0.12 bc | 5.81 ± 0.19 cd | 5.94 ± 0.18 b | |
| ND Concentration of P1 0.6 g/100 mL | contact time 60 ± 10 s | >5.52 | >5.52 | >5.52 | >5.52 | >5.22 | >5.52 |
| ND Concentration of P1 60 g/100 mL | <2.15 | <2.15 | <2.15 | <2.15 | <20.09 | <2.15 | |
| ND Concentration of P1 60 g/100 mL | contact time 300 ± 10 s | <2.15 | <2.15 | <2.15 | <2.15 | <2.15 | <2.15 |
| Preparation 2 (P2) | |||||||
| N | 6.99 ± 0.21 a | 6.95 ± 0.19 c | 6.97 ± 0.32 a | 7.02 ± 0.19 a | 5.89 ± 0.08 d | 5.98 ± 0.23 b | |
| NT | 6.91 ± 0.15 d | 6.83 ± 0.04 a | 6.86 ± 0.31 b | 6.89 ± 0.14 a | 5.80 ± 0.03 e | 5.90 ± 0.23 b | |
| NC | 6.90 ± 0.12 cd | 6.84 ± 0.05 b | 6.88 ± 0.35 b | 6.87 ± 0.09 b | 5.77 ± 0.04 d | 5.90 ± 0.27 a | |
| NW | 6.94 ± 0.11 bc | 6.87 ± 0.05 c | 6.90 ± 0.35 b | 6.91 ± 0.23 bc | 5.83 ± 0.32 a | 5.92 ± 0.32 b | |
| ND Concentration of P2 0.6 g/100 mL | contact time 60 ± 10 s | >5.52 | >5.52 | >5.52 | >5.52 | >5.22 | >5.22 |
| ND Concentration of P2 60 g/100 mL | 3.04 ± 0.12 a | <2.15 | <2.15 | <2.15 | <2.15 | <2.15 | |
| ND Concentration of P2 60 g/100 mL | contact time 300 ± 10 s | <2.15 | <2.15 | <2.15 | <2.15 | <2.15 | <2.15 |
| EN 13697:2015 (Phase 2 Stage 2) | |||
|---|---|---|---|
| Test Preparation | Treatment | Staphylococcus aureus ATCC 6538 | Pseudomonas aeruginosa ATCC 15442 |
| Preparation 1 (P1) | |||
| N | 6.79 ± 0.42 b | 6.77 ± 0.41 b | |
| NT | 7.17 ± 0.43 b | 7.17 ± 0.43 b | |
| NC | 7.20 ± 0.48 b | 7.19 ± 0.49 b | |
| NW | 7.20 ± 0.36 a | 7.21 ± 0.37 a | |
| ND Concentration of P1 14 g/100 mL | contact time 60 ± 10 s | 5.46 ± 0.37 a | 5.48 ± 0.23 b |
| ND Concentration of P1 21 g/100 mL | 5.22 ± 0.09 b | 5.38 ± 0.19 a | |
| ND Concentration of P1 28 g/100 mL | 4.95 ± 0.11 a | 5.00 ± 0.15 b | |
| ND Concentration of P1 35 g/100 mL | 3.92 ± 0.11 a | 4.74 ± 0.37 a | |
| ND Concentration of P1 42 g/100 mL | 2.85 ± 0.19 a | 3.51 ± 0.33 a | |
| ND Concentration of P1 49 g/100 mL | 2.33 ± 0.10 a | 2.46 ± 0.39 a | |
| ND Concentration of P1 56 g/100 mL | <0.10 | <0.10 | |
| ND Concentration of P1 63 g/100 mL | <0.10 | <0.10 | |
| ND Concentration of P1 70 g/100 mL | <0.10 | <0.10 | |
| Preparation 2 (P2) | |||
| N | 6.84 ± 0.41 b | 6.80 ± 0.10 ab | |
| NT | 7.22 ± 0.43 b | 7.16 ± 0.31 ab | |
| NC | 7.21 ± 0.49 b | 7.17 ± 0.21 ab | |
| NW | 7.22 ± 0.37 a | 7.18 ± 0.17 b | |
| ND Concentration of P2 14 g/100 mL | contact time 60 ± 10 s | 5.38 ± 0.14 a | 5.42 ± 0.33 a |
| ND Concentration of P2 21 g/100 mL | 5.03 ± 0.37 a | 5.26 ± 0.33 a | |
| ND Concentration of P2 28 g/100 mL | 4.91 ± 0.31 a | 4.83 ± 0.35 a | |
| ND Concentration of P2 35 g/100 mL | 2.76 ± 0.39 a | 2.87 ± 0.37 a | |
| ND Concentration of P2 42 g/100 mL | <0.10 | <0.10 | |
| ND Concentration of P2 49 g/100 mL | <0.10 | <0.10 | |
| ND Concentration of P1 56 g/100 mL | <0.10 | <0.10 | |
| ND Concentration of P2 63 g/100 mL | <0.10 | <0.10 | |
| ND Concentration of P2 70 g/100 mL | <0.10 | <0.10 | |
| Ethanol (E) | |||
| N | 6.76 ± 0.37 a | 6.77 ± 0.10 a | |
| NT | 7.19 ± 0.31 a | 7.18 ± 0.12 a | |
| NC | 7.21 ± 0.34 a | 7.20 ± 0.42 a | |
| NW | 7.21 ± 0.38 a | 7.21 ± 0.37 a | |
| ND Concentration of E 80 g/100 mL | 3.29 ± 0.29 a | 3.29 ± 0.30 a | |
| ND Concentration of E 90 g/100 mL | <0.10 | <0.10 | |
| ND Concentration of E 100 g/100 mL | <0.10 | <0.10 | |
| EN 1500:2013 | ||
|---|---|---|
| Test Preparation | Escherichia coli K12 NCTC 10538 | |
| Preparation 1 (P1) | Preparation 2 (P2) | |
| N | 8.63 ± 0.11 a | 8.63 ± 0.17 a |
| Nvb | 97 × 104 | 98 × 104 |
| B | 88 ± 0.23 b | 93 ± 0.43 b |
| Nv | 750 ± 0.31 a | 860 ± 0.21 a |
| C | 71 ± 0.28 a | 81 ± 0.13 a |
Publisher’s Note: MDPI stays neutral with regard to jurisdictional claims in published maps and institutional affiliations. |
© 2022 by the authors. Licensee MDPI, Basel, Switzerland. This article is an open access article distributed under the terms and conditions of the Creative Commons Attribution (CC BY) license (https://creativecommons.org/licenses/by/4.0/).
Share and Cite
Kucharski, Ł.; Cybulska, K.; Kucharska, E.; Nowak, A.; Pełech, R.; Klimowicz, A. Biologically Active Preparations from the Leaves of Wild Plant Species of the Genus Rubus. Molecules 2022, 27, 5486. https://doi.org/10.3390/molecules27175486
Kucharski Ł, Cybulska K, Kucharska E, Nowak A, Pełech R, Klimowicz A. Biologically Active Preparations from the Leaves of Wild Plant Species of the Genus Rubus. Molecules. 2022; 27(17):5486. https://doi.org/10.3390/molecules27175486
Chicago/Turabian StyleKucharski, Łukasz, Krystyna Cybulska, Edyta Kucharska, Anna Nowak, Robert Pełech, and Adam Klimowicz. 2022. "Biologically Active Preparations from the Leaves of Wild Plant Species of the Genus Rubus" Molecules 27, no. 17: 5486. https://doi.org/10.3390/molecules27175486
APA StyleKucharski, Ł., Cybulska, K., Kucharska, E., Nowak, A., Pełech, R., & Klimowicz, A. (2022). Biologically Active Preparations from the Leaves of Wild Plant Species of the Genus Rubus. Molecules, 27(17), 5486. https://doi.org/10.3390/molecules27175486

